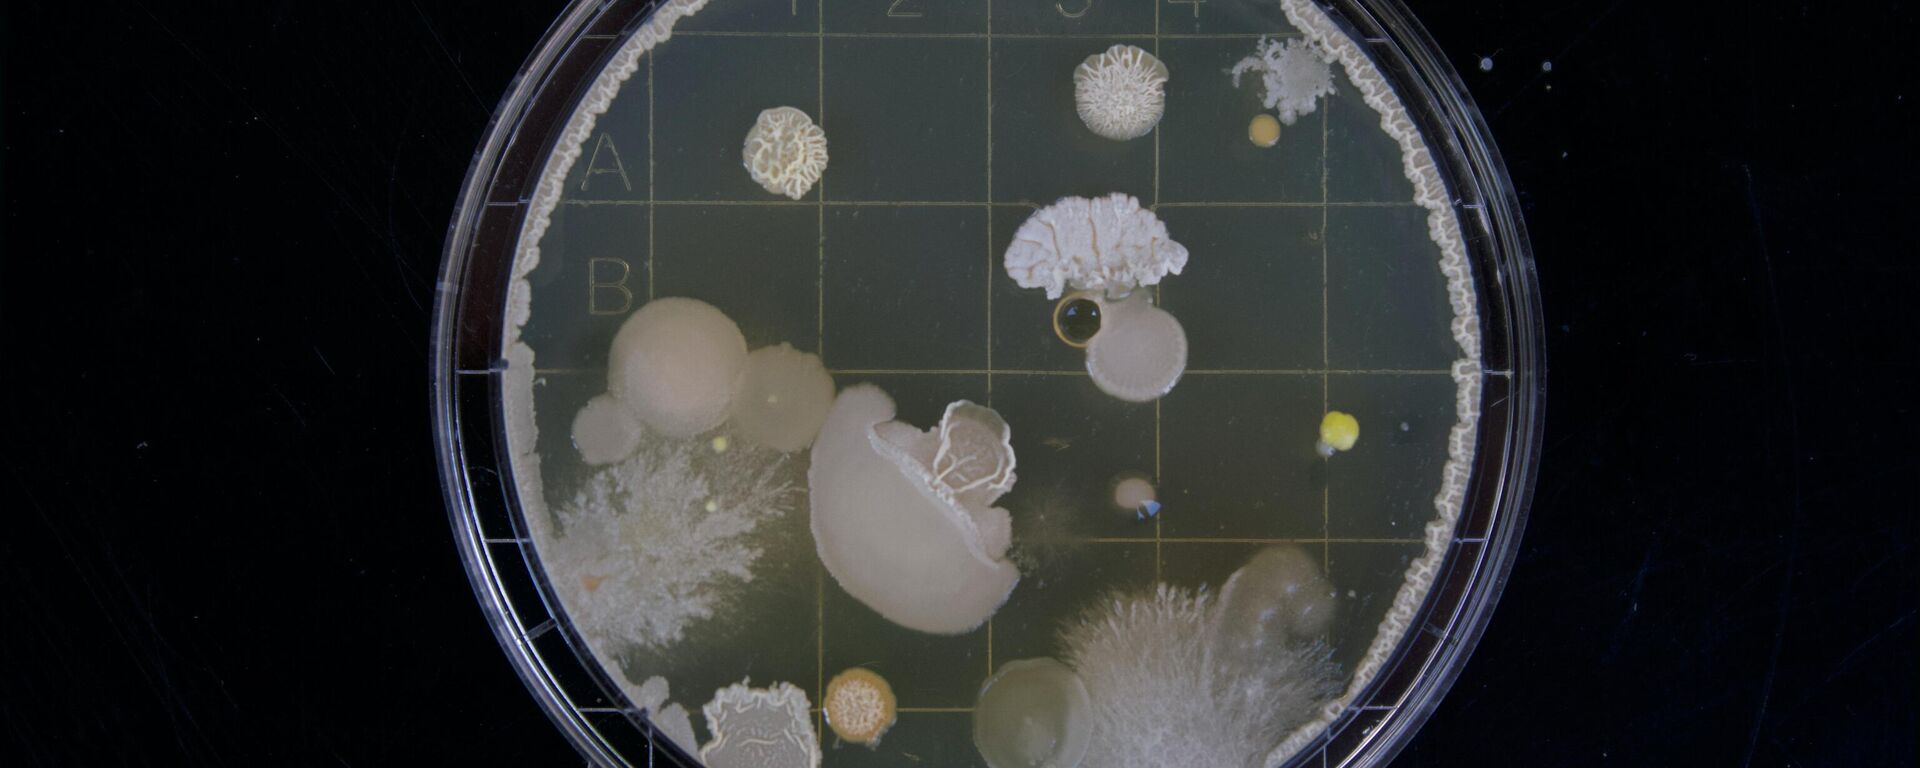
أحد أصناف البكتيريا داخل وعاء خاص - سبوتنيك عربي, 1920, 26.07.2025

https://sarabic.ae/20250728/علماء-روس-يطورون-دواء-قاتلا-للبكتيريا-العصوية--1103103805.html
علماء روس يطورون دواء "قاتلا للبكتيريا العصوية"
علماء روس يطورون دواء "قاتلا للبكتيريا العصوية"
سبوتنيك عربي
تمكن علماء روس من معهد سكريابين للكيمياء الحيوية وعلم وظائف الأعضاء للكائنات الدقيقة التابع للأكاديمية الروسية للعلوم، من عزل إنزيم غير معروف سابقًا من بكتيريا... 28.07.2025, سبوتنيك عربي
2025-07-28T08:57+0000
2025-07-28T08:57+0000
2025-07-28T08:57+0000
مجتمع
علوم
الصحة
أدوية
إنزيم
كائنات دقيقة
ميكروبات
الميكروبات
علماء
علماء روس
https://cdn.img.sarabic.ae/img/07e8/07/1b/1091183419_0:0:3072:1728_1920x0_80_0_0_b6f2ea0f9959e9718905866efa928b23.jpg
وأشارت الدراسة الجديدة إلى أن هذا الإنزيم يدمر جدران البكتيريا بكفاءة أعلى من البروتينات الأخرى ذات التأثير المماثل.وأكدت الدراسة أن تدمير جدران الخلايا يؤدي إلى موت الكائن الدقيق، ولا يمكنه تطوير مقاومة لهذا التأثير، كما هو الحال مع بعض المضادات الحيوية.وحدد العلماء إنزيما غير معروف سابقًا، والذي قد يشكل أساسًا لأدوية جديدة مضادة للميكروبات، حيث اكتشفوا أن بكتيريا "Lysobacter capsica" تنتج إنزيمًا لم يكن معروفًا من قبل، قادرًا على التأثير بشكل مدمر على جدران الخلايا البكتيرية. ونوهت الدراسة إلى أن دواءً يحتوي على إنزيم جديد، وهو "أميداز آمي" (Ami amidase)، يمكن أن يدمر خلايا مسببات التسمم الغذائي، ويستخدم لمكافحة الجمرة الخبيثة. واكتشف العلماء أيضًا الجين المسؤول عن إنتاج هذا البروتين، مما يمكّن من دمجه في خلايا بكتيريا "Lysobacter capsica" وزيادة كمية البروتين التي تنتجها.وفي المرحلة التالية، حصل العلماء على إنزيم " أميداز آمي" بكميات كافية لدراسته الشاملة. ولتحقيق ذلك، وباستخدام مناهج وراثية جزيئية مبتكرة، أجبر الباحثون خلايا "Lysobacter capsica" على إنتاج الكمية المطلوبة من إنزيم "أميداز آمي"، وقد أظهر الإنزيم نشاطًا عاليًا مضادًا للميكروبات ضد عدد من البكتيريا الممرضة، بما في ذلك السلالات المقاومة للمضادات الحيوية.وفي المستقبل، يخطط العلماء لتحديد بنية إنزيم "أميداز آمي" واستخدام هذه البيانات لتعديله، مما يتيح برمجة خصائص الأدوية.علماء روس يطورون أدوية لتحسين علاج الاضطرابات النفسية الحادةمنتشرة في العالم العربي... علماء روس يكشفون عن فوائد زهرة "القطيفة"
https://sarabic.ae/20241225/دراسة-تكشف-عن-ميكروبات-خطيرة-تعيش-في-أجهزة-الميكروويف--1096180441.html
https://sarabic.ae/20250726/علماء-روس-يروضون-البكتيريا-لتنتج-الأدوية-1103050182.html
سبوتنيك عربي
feedback.arabic@sputniknews.com
+74956456601
MIA „Rossiya Segodnya“
2025
سبوتنيك عربي
feedback.arabic@sputniknews.com
+74956456601
MIA „Rossiya Segodnya“
الأخبار
ar_EG
سبوتنيك عربي
feedback.arabic@sputniknews.com
+74956456601
MIA „Rossiya Segodnya“
سبوتنيك عربي
feedback.arabic@sputniknews.com
+74956456601
MIA „Rossiya Segodnya“
علوم, الصحة, أدوية, إنزيم, كائنات دقيقة, ميكروبات, الميكروبات, علماء, علماء روس, روسيا
علوم, الصحة, أدوية, إنزيم, كائنات دقيقة, ميكروبات, الميكروبات, علماء, علماء روس, روسيا
علماء روس يطورون دواء "قاتلا للبكتيريا العصوية"
تمكن علماء روس من معهد سكريابين للكيمياء الحيوية وعلم وظائف الأعضاء للكائنات الدقيقة التابع للأكاديمية الروسية للعلوم، من عزل إنزيم غير معروف سابقًا من بكتيريا "Lysobacter capsica"، والذي قد يشكل أساسًا لأدوية جديدة مضادة للميكروبات.
وأشارت الدراسة الجديدة إلى أن هذا الإنزيم يدمر جدران البكتيريا بكفاءة أعلى من البروتينات الأخرى ذات التأثير المماثل.
وأكدت الدراسة أن تدمير جدران الخلايا يؤدي إلى موت الكائن الدقيق، ولا يمكنه تطوير مقاومة لهذا التأثير، كما هو الحال مع بعض المضادات الحيوية.
وحدد العلماء إنزيما غير معروف سابقًا، والذي قد يشكل
أساسًا لأدوية جديدة مضادة للميكروبات، حيث اكتشفوا أن بكتيريا "Lysobacter capsica" تنتج إنزيمًا لم يكن معروفًا من قبل، قادرًا على التأثير بشكل مدمر على جدران الخلايا البكتيرية.

25 ديسمبر 2024, 14:12 GMT
وقالت إيرينا كودرياكوفا، الباحثة الرئيسية في مختبر الكيمياء الحيوية: "لقد عزلنا ووصفنا 12 إنزيمًا خارج الخلية لبكتيريا "Lysobacter capsica"، بما في ذلك إنزيمات تكافح العقديات والمكورات العنقودية والمعوية، بما في ذلك سلالات البكتيريا الممرضة المقاومة للمضادات الحيوية (الجراثيم المقاومة للمضادات الحيوية)، والإنزيم الجديد الثالث عشر فعال بشكل خاص ضد العصيات".
ونوهت الدراسة إلى أن دواءً يحتوي على إنزيم جديد، وهو "أميداز آمي" (Ami amidase)، يمكن أن يدمر خلايا مسببات التسمم الغذائي، ويستخدم لمكافحة الجمرة الخبيثة. واكتشف العلماء أيضًا
الجين المسؤول عن إنتاج هذا البروتين، مما يمكّن من دمجه في خلايا بكتيريا "Lysobacter capsica" وزيادة كمية البروتين التي تنتجها.
وفي المرحلة التالية، حصل العلماء على إنزيم " أميداز آمي" بكميات كافية لدراسته الشاملة. ولتحقيق ذلك، وباستخدام مناهج وراثية جزيئية مبتكرة، أجبر الباحثون خلايا "Lysobacter capsica" على إنتاج الكمية المطلوبة من إنزيم "أميداز آمي"، وقد أظهر الإنزيم نشاطًا عاليًا مضادًا للميكروبات ضد عدد
من البكتيريا الممرضة، بما في ذلك السلالات المقاومة للمضادات الحيوية.
وفي المستقبل، يخطط العلماء لتحديد بنية إنزيم "أميداز آمي" واستخدام هذه البيانات لتعديله، مما يتيح برمجة خصائص الأدوية.